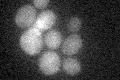
YOR122C
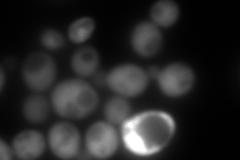
YOR122C
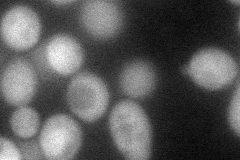
YOR122C
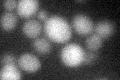
YOR122C

View description
Profilin, actin- and phosphatidylinositol 4,5-bisphosphate-binding protein, involved in cytoskeleton organization, required for normal timing of actin polymerization in response to thermal stress; localizes to plasma membrane and cytosol
Localization:
Intensity:
Fold change:
Significance:
-
C’ GFP library in SD
below threshold16.45 -
N' NOP1pr-GFP in SD

cytosol137.355 -
N' TEF2pr-mCherry in SD
cytosol14.2098 -
N' NATIVEpr-GFP in SD

cytosol128.198 -
N' TEF2pr-VC and Cyto-VN in SD
cytosol57.0402 -
C’ GFP library in SD+DTT
cytosol13.430.81No -
C’ GFP library in SD+H2O2

cytosol15.310.93No -
C’ GFP library in Starvation Media

cytosol15.470.94No -
C’ GFP library on the background of Pup2-DaMP

N/A -
C’ GFP library on the background of CCT mutant

N/A0N/AYes
